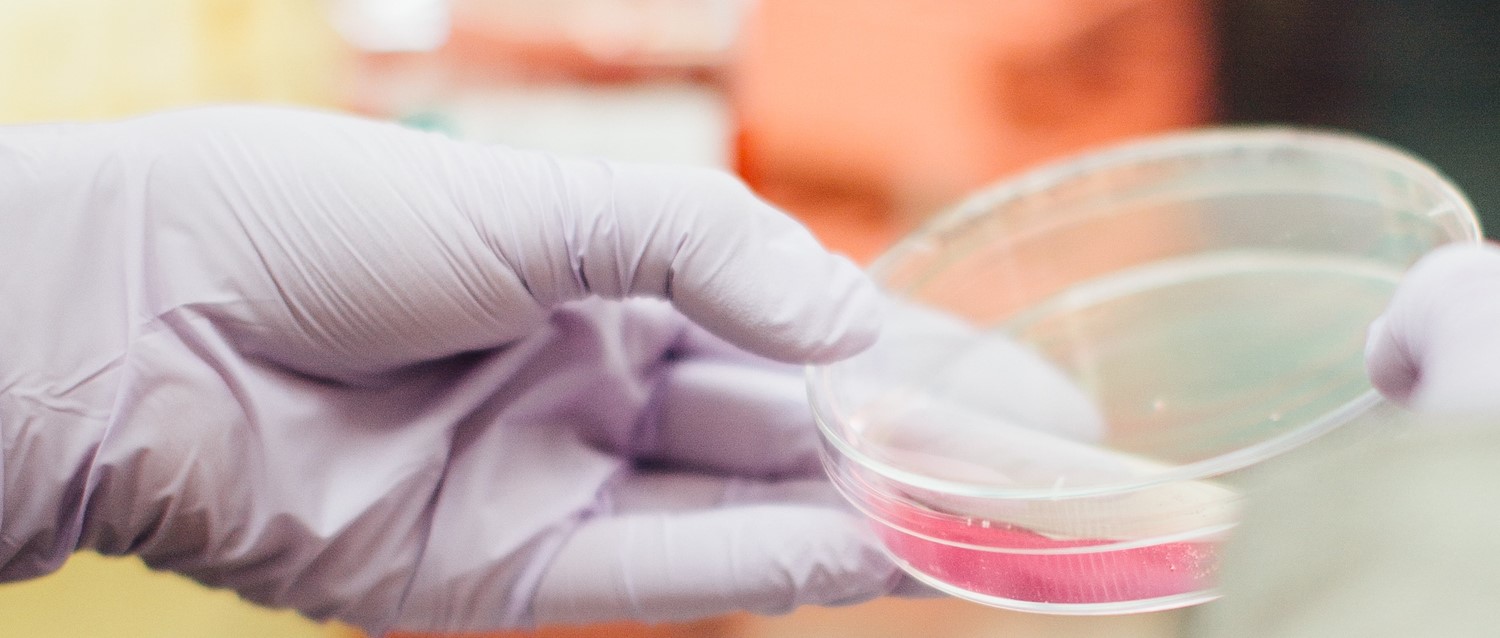
New blood test may detect aggressive prostate cancer

PSA testing options
Peer reviewed by Dr Adrian Bonsall, MBBSAuthored by Dr Colin Tidy, MRCGPOriginally published 19 Sept 2017
Meets Patient’s editorial guidelines
- DownloadDownload
- Share
- Language
- Discussion
- Audio Version
- Add to preferred sources on Google
The prostate specific antigen (PSA) test is a blood test used to see if you might have prostate cancer and to monitor treatment for prostate cancer. The PSA test does not tell you for certain whether you have prostate cancer.
In this article:
Continue reading below
Should I have a prostate specific antigen (PSA) test?
Having the PSA test may sometimes cause you more harm than benefit. It is therefore very important to consider whether having the PSA test is right for you. See also separate leaflets called PSA Testing for Prostate Cancer and Prostate Cancer.
Benefits and risks of having or not having a PSA test.
Frequently asked questions | Having a PSA test | Not having a PSA test |
How does having a PSA test affect my chance of being diagnosed with prostate cancer? | Having the PSA test increases the chance of prostate cancer being diagnosed. Between 6 and 7 men in every 100 who have a PSA test are diagnosed with cancer. The PSA test finds many cancers that would not cause any health problems if they remained un-diagnosed and untreated. Therefore having the test may cause unnecessary worry as well as unnecessary investigations and treatment. | Between 4 and 5 men in every 100 who don’t have a PSA test are diagnosed with prostate cancer at some time in the future. Not having a PSA test will mean you do not have any unnecessary worry, investigations or treatment. |
What is the effect of having a PSA test on prostate cancer being diagnosed earlier? | Prostate cancer is diagnosed on average between 6 and 8 years earlier in men who have a PSA test than those who don’t have the test. | It is not known whether early diagnosis and treatment makes any difference to how long you are likely to live if you do have prostate cancer. |
What is the effect of having a PSA test on dying from prostate cancer? | Men who have prostate cancer are less likely to die of prostate cancer if they have a PSA test. Having a PSA test prevents 1 death from prostate cancer for every 1,000 men who have the test. The risk of dying from prostate cancer over the next ten years is between 4 and 5 in 1,000 for men who have the PSA test. | The risk of dying from protstate cancer over the next ten years is 5 in 1,000 for men who do not have the PSA test. The risk of dying from prostate cancer is (at best) 1 in 1,000 less if you have the PSA test than if you don’t have the test. |
What is the effect of having a PSA test on how long you live? | Studies have shown that men who have the PSA test do not on average live longer or shorter lives than men who do not have the PSA test. | Studies have shown that men who do not have the PSA test do not on average live longer or shorter lives than men who have the PSA test. |
What is the harm of a positive PSA test result? | If you have a positive PSA test result (a high PSA level) you will be referred to a specialist for further investigations and possibly for treatment of prostate cancer. Investigations: about 70 men in every 100 with a raised PSA level will have a biopsy of the prostate. A biopsy of the prostate can cause pain, bleeding and urine infections. Treatment: problems with treatment for prostate cancer include incontinence of urine and difficulty getting an erection. There may also be complications caused by having an operation or radiotherapy for the prostate cancer. | If you do not have the test you will not then be referred to a specialist for further investigations and possibly for treatment of prostate cancer. |
What is the risk of a positive result being wrong (called a false positive result)? A false positive result is when the test indicates you do have prostate cancer but you do not have prostate cancer. | About 70 men in every 100 with a raised PSA result do not have prostate cancer. | Not having a PSA test may avoid the unnecessary anxiety of having an abnormal result when you don’t actually have prostate cancer. |
What is the risk of a negative result being wrong (called a false negative result)? A false negative result is when the test indicates you do not have prostate cancer but you do have prostate cancer. | About 15 in every 100 men who have a normal PSA level do have prostate cancer. | Not having a PSA test may avoid false reassurance when a false negative result wrongly indicates that you do not have prostate cancer. |
Patient picks for Male cancer
Cancer
New blood test may detect aggressive prostate cancer
A new blood test has been found to accurately detect the presence of aggressive prostate cancer, according to research by Queen Mary University of London.
by Ashwin Bhandari

Cancer
Why are Black men more likely to die from prostate cancer?
Each year, about 52,000 men are diagnosed with prostate cancer in the UK. However, Black men are at higher risk of prostate cancer than other men. 1 in 4 Black men will get prostate cancer in their lifetime. This is double the 1 in 8 risk of other men.
by Emily Jane Bashforth
Continue reading below
About the authorView full bio

Dr Colin Tidy, MRCGP
General Practitioner, Medical Author
MBBS, MRCGP, MRCP (Paediatrics), DCH
Dr Colin Tidy is an NHS Doctor, based in Oxfordshire.
About the reviewerView full bio

Dr Adrian Bonsall, MBBS
Medical Author
MA (Chemistry), MBBS (Hons), DCH
Since 2000 Adrian has been employed in emergency and critical care paediatrics based in Sydney, with particular interests in toxicology, trauma and resuscitation.
Article history
The information on this page is peer reviewed by qualified clinicians.
19 Sept 2017 | Originally published
Authored by:
Dr Colin Tidy, MRCGPPeer reviewed by
Dr Adrian Bonsall, MBBS

Ask, share, connect.
Browse discussions, ask questions, and share experiences across hundreds of health topics.

Feeling unwell?
Assess your symptoms online for free
Sign up to the Patient newsletter
Your weekly dose of clear, trustworthy health advice - written to help you feel informed, confident and in control.
By subscribing you accept our Privacy Policy. You can unsubscribe at any time. We never sell your data.
More in cancer
- Cancer fatigue: what it is and how to cope
- End of life care: medical, emotional and spiritual support
- Everything you need to know about cancer screening
- How do we screen for bowel cancer?
- How to cope with a terminal illness at Christmas
- How to look after your hair during chemotherapy
- How to look after your skin during chemotherapy
- How to talk about your end of life care wishes
- Just one year of being overweight lowers chances of cancer survival
- Less survivable cancers are more likely to have late diagnoses
- New blood test may detect aggressive prostate cancer
- Specialist cancer treatment in the comfort of your own home
- Stories of Cancer and Hope: giving voice to lives affected by cancer
- Urine test for prostate cancer could reveal who needs urgent treatment
- What are the early warning signs of bowel cancer?
- What is Movember?
- What it's like to have breast cancer when you're a man
- What to expect during a breast screening
- Whole body 3D mole mapping: the future of skin health?
- Why are Black men more likely to die from prostate cancer?